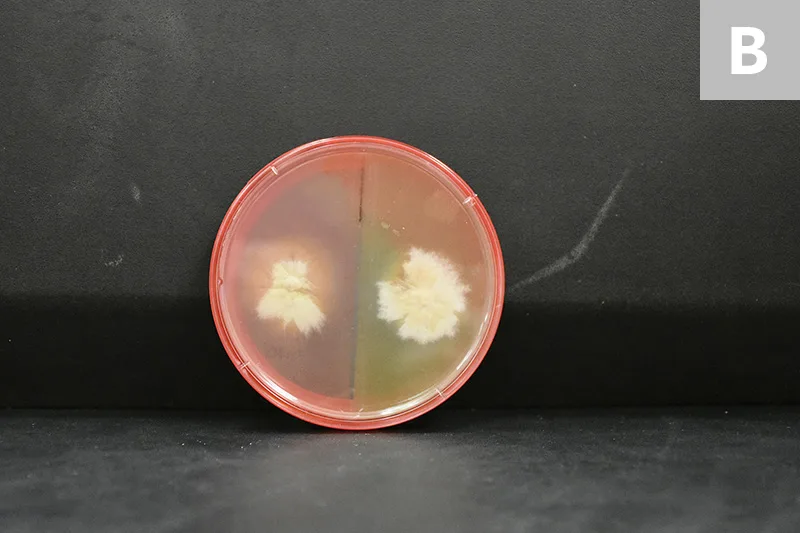
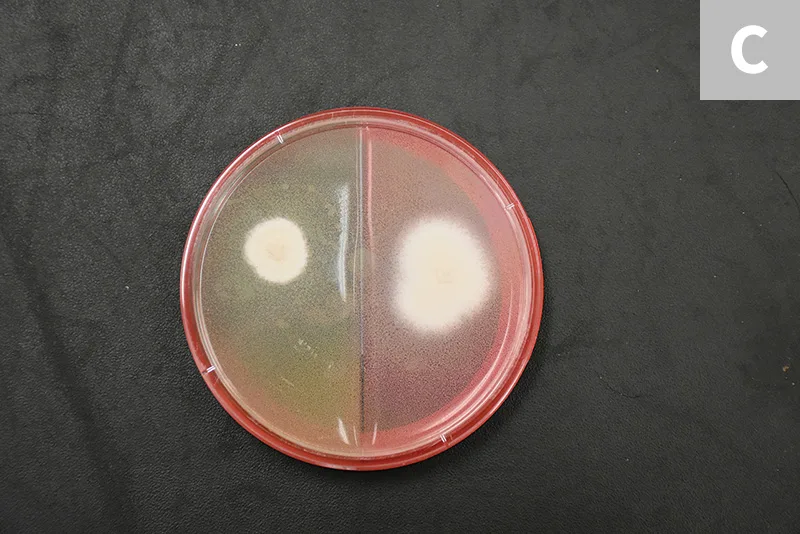
Two round white colonies growing on either side of a split agar plate.

Fungal Cultures
Selene A. Jones, DVM, University of Tennessee
Elizabeth R. May, DVM, DACVD, University of Tennessee

Fungal cultures are an important diagnostic tool that can be easily performed in a general practice setting.1-3 It is essential to include dermatophytosis in the differential diagnoses for patients with clinical signs consistent with fungal skin infection (eg, multifocal patchy alopecia, crusts, scales, pustules, papules), as well as for patients with similar clinical signs (ie, demodicosis, pyoderma) that fail to respond to appropriate therapy.1-7 Yorkshire terriers, working dogs, hunting dogs, and Persian cats may be predisposed to dermatophytosis.3,4,7
Sample collection for fungal cultures typically involves a hair pluck, which is best performed at lesional margins,1-4,7 or a sterile toothbrush.1,2,4,6,7 A sterile toothbrush is recommended for cats and to detect subclinical carriers that lack obvious lesions (eg, cats passively carrying infectious fungal elements that pose a risk to human health and environmental contamination).1-4,6 Any commercial toothbrush in its original packaging is considered mycologically sterile for this use.
Flat culture plates represent the best medium to use, ideally when divided into 2 compartments: dermatophyte test medium, which selects for dermatophytes, and Sabouraud dextrose agar, which encourages sporulation and thus facilitates identification via microscopy.1,2,4,7 The shape of other collection containers (eg, jars, tubes) can make inoculation of organisms challenging. In addition, these containers have tight-fitting lids that can encourage bacterial growth by trapping moisture,1,2,4 and obtaining samples from these containers to identify fungal macroconidia can be difficult.4
Dermatophytes grow best in media slightly above room temperature (ie, 75°F-86°F [24°C-30°C]).1-4,7 Ultraviolet light and low humidity prevent growth on culture media.1,2,4 Cultures should be kept in a dark drawer or cabinet with a small dish of water nearby.4 Most dermatophytes grow within 2 to 7 days; however, culture plates should be kept for 21 days in case slow-growing variants (eg, Trichophyton spp) are present or if antifungal therapy was initiated prior to sampling.1-3
Although certain culture media are selective for dermatophytes, contaminant saprophytes can develop and be mistaken for dermatophytes.1,2,4,5,7 Colony morphology, media color change, and microscopic morphology are the best indicators to differentiate pathogens from contaminants.1-4 Dermatophyte colonies are white-to-pale in color and fluffy in appearance; saprophytes are often pigmented.1-3 Color change is caused by a pH indicator within the medium that modifies the color during protein metabolism.1,2,4 Because dermatophytes prefer protein (eg, keratin), a color change to red should correspond with colony growth consistent with the expected pathogen.1,2,4 Saprophytes prefer carbohydrates and only use protein if carbohydrates are depleted1,2,4; therefore, color change can still occur, but not alongside initial colony growth.4 Daily observation during prolonged incubation (ie, >10 days) is imperative because saprophytic fungi will eventually cause the distinctive color change to red.1,2,4
Microscopic evaluation of macroconidia is the definitive technique for confirming dermatophytosis.4 There is a high likelihood of misdiagnosis if microscopy and macroscopic characteristics are not considered.7 The most common dermatophytes that infect small companion animals are Microsporum canis, Microsporum gypseum, and Trichophyton mentagrophytes.1-3,5,6
PCR is currently being investigated as a means of diagnosing dermatophytosis, with results available in 1 to 3 business days versus the 1 to 3 weeks required for final dermatophyte culture results; panels include more than one dermatophyte species and demonstrate high sensitivity and high specificity.5 Research into the value of PCR as a sole diagnostic tool is ongoing, and fungal culture is still considered the gold standard.
Step-by-Step: Fungal Cultures1-4,7
What You Will Need
Sterile hemostat (ie, hair pluck) or new sterile toothbrush
Divided dermatophyte test medium or Sabouraud dextrose agar plate
Warm (ie, 75°F-86°F [24°C-30°C]), dark area
Small dish of water
Clear acetate tape
Lactophenol cotton blue or new methylene blue stain
Light microscope
Step 1
Use a sterile hemostat (ie, hair pluck) or a new sterile toothbrush to obtain culture samples.
Hair-Pluck Technique (Recommended in Animals with Active Lesions)
Using a sterile hemostat, pluck hairs (≈10-20) from the periphery of lesional skin; the hair bulb and root must be intact. Gently place plucked hair on the culture medium. Ensure the plucked hair remains in place and in contact with the agar by applying gentle pressure with the sterile hemostat (A).
Toothbrush Technique (Recommended in Cats & Animals without Obvious Lesions)
Brush a sterile toothbrush through the animal’s hair coat, against the direction of growth, for approximately 30 strokes. Lightly press the bristles onto the culture medium (B).


Author Insight
Broken or misshapen hair and/or hair from inflamed, scaled, or crusted areas are preferred for sampling. Avoid areas that have been recently medicated.
Step 2
Incubate the closed culture plate in a warm (ie, 75°F-86°F [24°C-30°C]), dark area for 21 days. Place a small dish of water nearby to provide humidity and prevent the medium from drying out. Check the medium daily for fungal growth.

Grossly, colonies of M canis are typically white with a cotton-like texture. As they age, they can become powdery and develop a centrally depressed area with radial folds (A; colony on split dermatophyte test medium and Sabouraud dextrose agar plate).
M gypseum appears pale-to-light-brown with a flat-to-granular texture. White mycelia can also form (B; colony on split dermatophyte test medium and Sabouraud dextrose agar plate).
The colony morphology of T mentagrophytes is variable. Most zoophilic forms will be white to cream in color with a powdered appearance, whereas the anthrophilic forms typically appear white with a cotton-like texture (C; colony on split dermatophyte test medium and Sabouraud dextrose agar plate).
Author Insight
Contaminant fungi can cause color change, usually after prolonged incubation (ie, >10 days). Correct interpretation happens when a red color change occurs simultaneously with colony growth; however, making a premature diagnosis based on color change alone can lead to misdiagnosis and unnecessary treatment and potentially delay the ability to render a definitive diagnosis.
Step 3
Identify growth on the culture to rule out erroneous results. While wearing gloves, collect macroconidia by gently applying the sticky side of a piece of clear acetate tape to the top of the colony. Place several drops of lactophenol cotton blue stain (as used in the samples shown) or new methylene blue stain on a microscope slide, then place the tape, sticky side down, over it. After placing a coverslip on top, evaluate the sample under the microscope. Alternatively, the entire culture plate can be sent to a diagnostic or commercial laboratory for dermatophyte identification.


M canis forms spindle-shaped macroconidia with thick walls and a knob at the terminal end; 6 or more cells per macroconidia are present (A, 20×; B, 100× oil immersion).


M gypseum forms spindle-shaped macroconidia with thin walls and lacks a knob at the terminal end; 6 or fewer cells per macroconidia will be present (C, 20×; D, 100× oil immersion).


T mentagrophytes macroconidia are often cigar-shaped with thin walls; some isolates will have spiral hyphae. Globoid microconidia arranged singly or in clusters along hyphae can also be seen (E, 20×; F, 100× oil immersion).